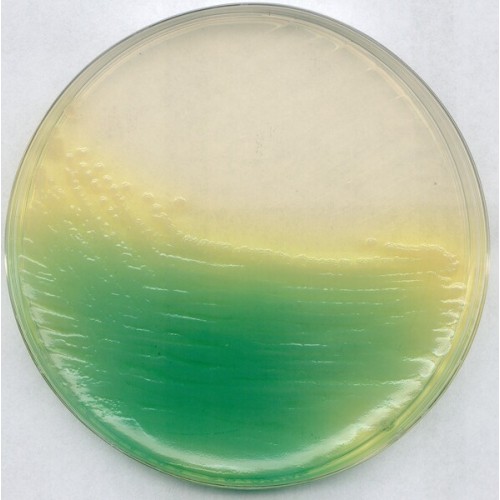

KING AGAR BASE 500GR MERCK
Modelo: 1109910500
-
R$3.178,06
ou até 3x de R$1.059,35 sem juros
Economize 5% no PIX: R$3.019,16
ou 3.5% no boleto: R$3.066,83
Descrição
KING AGAR B BASE MERCK
RENDIMENTO 33,5g/l ACC TO DANK STANDARD
EMBALAGEM 500GR
Mode of Action
See Pseudomonas Agar F Base (MERCK, Cat. No. 1.10989.). Substitution of di-potassium hydrogen phosphate (which is recommended in the Dansk Standard) by tri-potassium phosphate 3-hydrate prevents decrease in pH after autoclaving and resulting decrease in the development of fluorescein.
Typical Composition (g/litre)
Proteose peptone 20.0; magnesium sulfate 1.5; tri-potassium phosphate 3-hydrate 1.8; agar-agar 10.0.
Also to be added: Glycerol 10.0 g/litre.
Preparation
Suspend 33.5 g/litre together with 10 g glycerol/litre, autoclave (15 min at 121 °C).
pH: 7.1 ± 0.2 at 25 °C.
The plates are clear and yellowish-brown.
RENDIMENTO 33,5g/l ACC TO DANK STANDARD
EMBALAGEM 500GR
Mode of Action
See Pseudomonas Agar F Base (MERCK, Cat. No. 1.10989.). Substitution of di-potassium hydrogen phosphate (which is recommended in the Dansk Standard) by tri-potassium phosphate 3-hydrate prevents decrease in pH after autoclaving and resulting decrease in the development of fluorescein.
Typical Composition (g/litre)
Proteose peptone 20.0; magnesium sulfate 1.5; tri-potassium phosphate 3-hydrate 1.8; agar-agar 10.0.
Also to be added: Glycerol 10.0 g/litre.
Preparation
Suspend 33.5 g/litre together with 10 g glycerol/litre, autoclave (15 min at 121 °C).
pH: 7.1 ± 0.2 at 25 °C.
The plates are clear and yellowish-brown.